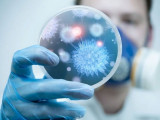
ينفەكتسيونيست-پروفەسسور: زەرتحانالار قورىتىندىسىنا كۇمانمەن قارايمىن

الەم • 01 ءساۋىر, 2020
Walt Disney باسشىلارى جالاقىلارىنان باس تارتتى
The Walt Disney Company باسشىلىعى پاندەميا كەزەڭىندەگى قيىن-قىستاۋ ۋاقىتتاردا كومپانياعا قولداۋ ءبىلدىرۋ ءۇشىن ايلىق جالاقىلارىنان باس تارتتى. بۇل تۋرالى «The Hollywood Reporter» سايتى حابارلادى.
قوعام • 01 ءساۋىر, 2020
ينفەكتسيونيست-پروفەسسور: زەرتحانالار قورىتىندىسىنا كۇمانمەن قارايمىن
قازىرگى جاعادايدا ينفەكتسيونيست-دارىگەرلەردىڭ ءاربىر ويى, پىكىرى قوعام ءۇشىن ماڭىزدى بولىپ تۇر. جۇقپالى اۋرۋحانالارداعى جۇمىسى قاۋىرت قىزمەتكەرلەردىڭ تەلەفونمەن تىلدەسۋگە دە مۇرشاسى جوق ەكەن. دەسە دە ءبىراز ىزدەنىسىمىزدەن سوڭ 40 جىل بويى ەلىمىزدەگى جۇقپالى اۋرۋلاردى ەمدەگەن, زەرتتەگەن جانە قانشاما ينفەكتسيونيست-دارىگەرلەردى تاربيەلەپ شىعارعان عالىم, دارىگەر, مەديتسينا عىلىمدارىنىڭ دوكتورى, پروفەسسور عاليا عابدۋللاقىزىمەن سۇحباتتاسۋدىڭ ءساتى ءتۇستى.
ايماقتار • 01 ءساۋىر, 2020
قىزىلوردا: تاعى 6 ادامنىڭ بويىنان ۆيرۋس تابىلدى
قىزىلودا وبلىسىندا كوروناۆيرۋس ينفەكتسياسىنا شالدىققاندار سانى 24 ادامعا جەتتى. بۇل تۋرالى وبلىستىق دەنساۋلىق ساقتاۋ باسقارماسىنىڭ باسشىسى جاقسىلىق ابدىسامەتوۆ حابارلادى.
ايماقتار • 01 ءساۋىر, 2020
مەملەكەتتىك قىزمەتتىڭ 608 ءتۇرىن ەلەكتروندىق ۇكىمەت پورتالى ارقىلى الۋعا بولادى
قاۋىپتى ينفەكتسياسىنىڭ تارالۋىن بولدىرماۋ ءۇشىن قازاقستاندا حالىققا قىزمەت كورسەتۋ ورتالىقتارىنىڭ جۇمىسى توقتاتىلعانى بەلگىلى. دەگەنمەن مەملەكەتتىك قىزمەتتەردى ەلەكتروندى فورماتتا الۋ قولجەتىمدى. «ازاماتتارعا ارنالعان ۇكىمەتتىڭ» الماتى فيليالى ونلاين-كەڭەسشىلەردىڭ سانىن ارتتىرىپ وتىر.
ايماقتار • 01 ءساۋىر, 2020
جامبىل وبلىسىندا جالعان اقپارات تاراتقان ادام ۇستالدى
جامبىل وبلىسىندا جالعان اقپارات تاراتقان تۇرعىن ۇستالدى. ول الەۋمەتتىك جەلىلەر ارقىلى «دۇيسەنبىدەن باستاپ شۋ رەسمي تۇردە كارانتينگە جابىلادى» دەگەن جالعان اقپارات جاريالاعان.